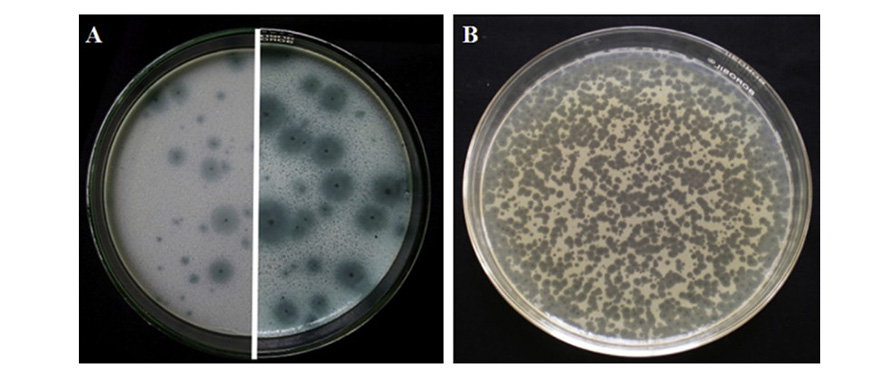
thể thực khuẩn

Ứng dụng thể thực khuẩn để kiểm soát bệnh phát sáng trên ấu trùng tôm sú. Ảnh minh họa
Thể thực khuẩn - khắc tinh của vi khuẩn Vibrio
Liệu pháp bacteriophage (thể thực khuẩn) là một trong những kỹ thuật có khả năng kiểm soát và loại bỏ vi khuẩn Vibrio spp. gây bệnh trên động vật thủy sản.
Nhiều phát hiện về sự tồn tại của phage ở hệ thống nuôi tuần hoàn (RAS) sau 3 tuần nuôi, nồng độ thể thực khuẩn cao nhất trong các lớp màng sinh học trên bề mặt nhựa, điều này cho thấy tiềm năng ứng dụng của liệu pháp phage trong RAS là rất lớn.
Tại một trang trại nuôi tôm ở bờ biển phía tây của Ấn Độ. Ứng dụng thể thực khuẩn để kiểm soát bệnh phát sáng (Vibrio harveyi) trên ấu trùng tôm sú (Penaeus monodon) đã được thử nghiệm. Ấu trùng tôm được xử lý với 100 ppm phage hai lần giúp làm giảm mật số Vibrio harveyi. Tỷ lệ sống của ấu trùng đạt 80% khi điều trị bằng thể thực khuẩn.

Bacteriophage tiêu diệt mầm bệnh vi khuẩn bằng chu trình tan (lytic cycle). Nguồn Ninawe và ctv., 2020
Một nghiên cứu khác đã phân lập được 4 chủng thể thực khuẩn, gồm Viha9, Viha10, Viha11 từ hàu và Viha8 từ nước trong trại giống. Đặc điểm hình thái của cả hai phage Viha8 và Viha10 đều có đuôi và chứa DNA sợi kép, do đó cả hai phage đều được xác nhận là thành viên của họ Siphoviridae. Sử dụng đơn và kết hợp Viha8 và Viha10 làm biện pháp kiểm soát sinh học đối với Vibrio harveyi trong sản xuất giống tôm sú. Phác đồ điều trị bổ sung ngày thứ ba với Viha10 và ngày thứ tư với Viha8. Kết quả cho thấy tỷ lệ sống của ấu trùng tôm sú trong bể xử lý bằng thể thực khuẩn là 86-88%.
Phage pVp-1 được phân lập từ nước ven biển Hoàng Hải ở Hàn Quốc, đã chứng minh hiệu quả trong việc kiểm soát các loài Vibrio. Ngoài ra, loại thể thực khuẩn này cũng được báo cáo là có khả năng lây nhiễm hiệu quả đối với vi khuẩn Vibrio parahaemolyticus ATCC33844, một chủng gây bệnh được phân lập từ tôm nuôi ở Nhật Bản. Ngoài ra, chủng phage pVp-1 được sử dụng để chống lại một chủng V. parahaemolyticus đa kháng kháng sinh (CRS09-17).
Các mảng phage hình thành tiêu diệt V. parahaemolyticus.
Liệu pháp thể thực khuẩn chống lại vi khuẩn V. splendidus nhiễm trên hải sâm (Apostichopus japonicus) và các thử nghiệm chống lại V. coralliilyticus trên san hô (Acropora millepora) được thực hiện. Trong trường hợp của V. splendidus, ba thể thực khuẩn có tên PVS-1, PVS-2 và PVS-3 có thể ức chế sự phát triển 3 loài Vibrio khác. Một hỗn hợp phage gồm các phage này làm tăng tỷ lệ sống của hải sâm bị nhiễm vi khuẩn V. splendidus từ 18% lên 82%. Một thử nghiệm tương tự cũng được sử dụng để ngăn ngừa nhiễm V. cyclitrophicus, một loại thực khuẩn có tên vB VcyS_Vc1 đã có thể giúp tăng tỷ lệ sống của hải sâm non từ 18% lên 81%, 58% và 63%.
Phage cũng đã được sử dụng để bảo vệ chống lại nhiễm V. anguillarum gây bệnh trên cá, phage giúp gia tăng tỷ lệ sống của cá từ 60 đến 100% sau khi nhiễm bệnh 20 ngày; đây là nỗ lực thành công đầu tiên để chứng minh việc sử dụng thể thực khuẩn kiểm soát mầm bệnh Vibrio ở loài salmonids. Một thử nghiệm tương tự trên ấu trùng cá ngựa vằn trong mô hình lây nhiễm, tỷ lệ chết của cá ngựa vằn khi sử dụng phage để điều trị V. anguillarum là dưới 3%, trong khi ấu trùng bị nhiễm không có phage cho thấy tỷ lệ chết là 17%. Gần đây hơn, có báo cáo rằng hai thể thực khuẩn ϕSt2 và ϕGrn1 chống lại V. alginolyticus trong mô hình nuôi Artemia salina.
Ngoài ra, thể thực khuẩn còn kiểm soát bệnh Vibrio spp. ở tôm hùm, như trong nuôi ấu trùng của tôm hùm đá (Panulirus ornatus) và tôm hùm gai. Thể thực khuẩn cũng được sử dụng để kiểm soát vi khuẩn V. harveyi và Vibrio alginolyticus gây bệnh trên ngọc trai.
Tuy nhiên, một trở ngại lớn khác đối với liệu pháp thực khuẩn là tiêu chuẩn/quy định cụ thể được thiết kế dựa trên bản chất đặc biệt của thể thực khuẩn. Mặc dù thể thực khuẩn được coi là sử dụng như chất chống vi khuẩn, chúng có các tính năng đặc biệt là tự sao chép, tự hạn chế và không có độc tính và do đó không thể được phân loại hoặc quy định như thuốc kháng sinh.
Việc thiếu kiến thức và quy định đã dẫn đến thể thực khuẩn được xếp vào nhóm các chất khó thực hiện các thử nghiệm lâm sàng. Nói cho cùng thể thực khuẩn là một liệu pháp hiệu quả và có thể ứng dụng trong nuôi trồng thủy sản chống lại vi khuẩn gây bệnh đặc biệt là nhóm vi khuẩn Vibrio.

_1769663497.jpg)
_1768458979.jpg)
_1768297695.jpg)
_1766652211.jpg)

